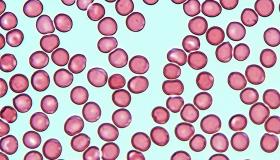
Image

国际计量

原始发布时间: 2016-06-14
采集时间:
ANSTO
Published on the 14th June 2016 by ANSTO Staff
The National Computing Infrastructure (NCI) has highlighted to the work of environmental researcher Andrew Smith with an article on its website. It takes the power of Australia's world-class high-end supercomputer, Raijin to model some of…

原始发布时间: 2022-09-20
采集时间:
INMETRO
Participam da operação nesta terça-feira equipes do Inmetro, Senacon, ANP, Procon-RJ, Polícia Federal, Detran/RJ e a Polícia Militar
Como parte da Operação Petróleo Real, que acontece até quinta-feira (22) em todo o país, sob coordenação do Ministério da Justiça e Segurança Pública (MJSP), o…

原始发布时间: 2022-09-20
采集时间:
MIKES-FMI
The soil carbon model Yasso produced by the Finnish Meteorological Institute has many influential climate-change-related applications in Finland and abroad. For example, the Yasso model is used for greenhouse gas inventories and future scenarios and for evaluating the effects of various measures in…

原始发布时间: 2022-09-30
采集时间:
MIKES-FMI
Understanding aerosol-cloud interactions in stratocumulus: a successful story about synergistic interactions in atmospheric science
A study recently published in Atmospheric Chemistry and Physics offers an insightful analysis of the role of aerosol in the formation of clouds.…

原始发布时间: 2022-09-29
采集时间:
NILU
Birkenes Observatory. Photo: Kjetil Samuelsen, FVN
Updated 30 September: NILU scientists first estimated that the total methane leaks from the Nord Stream gas pipes could be at least 40 000 tons. New estimates as of 30 September brings that number up to at least 80 000 tons.…

原始发布时间: 2017-05-26
采集时间:
NIVA
EU Water Framework Directive gives specific goals that Member States are obliged to reach. But in a changing climate, with increasingly frequent and extreme weather and climate events, how is water management effectuated?
Several of the EU directives have been implemented in Norway, although the…
原始发布时间: 2022-06-01
采集时间:
PTB
Accurate measurement of the concentration of cells in blood is important for diagnosis or therapy monitoring of many diseases. The comparability of the measurement results within a laboratory and between different laboratories is critical for patient safety. To assure comparability of the…

原始发布时间: 2022-09-14
采集时间:
MIKES-FMI
Black carbon emissions give rise to a positive radiative forcing, thereby warming the climate. A new study shows that, for a given amount of emissions, the radiative forcing depends strongly both on the location and season of the emissions.
The snow radiative forcing is generally negligible for…

原始发布时间: 2022-09-16
采集时间:
MIKES-FMI
News 16.9.2022
The result of a new study shows that the summertime evaporation over the surface of a glacial lake can be much greater than earlier estimated. Results help to develop more accurate weather prediction systems in Antarctica.
Photo: Dmitrii Emelyanov
Evaporation is a result of…

原始发布时间: 2020-03-25
采集时间:
NIVA
A new research project has looked at microplastics in marine bivalves from 100 sites spread throughout much of the Nordic waters. Microplastics were found in 4 of the 5 bivalve species investigated, and there was a huge variation in the occurrence and type of microplastics.
This report, just…

原始发布时间: 2021-06-10
采集时间:
NIVA
Something has happened in the ocean – completely out of view – that destroyed Norway’s kelp forests across an estimated 8400 km2.
We all think about deforestation and the devastating disappearance of forests on land, from the burning of the Amazon to wildfires in southern Europe, Siberia and…

原始发布时间: 2020-07-09
采集时间:
NIVA
While ocean acidification was initially perceived as a threat only to the marine realm, the authors of a new publication argue that it is also an emerging human health issue.
The global threats from carbon dioxide (CO2) accumulating in the world’s oceans and driving ongoing ocean acidification are…

原始发布时间: 暂无
采集时间:
LNE-CETIAT
CETIAT's services cover a wide range of operations on measuring instruments and sensors: calibration, adjustment, checking and control in laboratory and on your site.
CETIAT's scientific expertise relies on 3 national standards, ISO 17025 accredited laboratories and capacities for 6 physical…

原始发布时间: 2022-07-27
采集时间:
MIKES-FMI
News 27.7.2022
Microclimate temperature variability considerable in boreal forests and the oroarctic tundra
The study published in the Agricultural and Forest Meteorology journal examined the temperatures of microclimates in northern environments based on observations from nearly…

原始发布时间: 2022-07-28
采集时间:
MIKES-FMI
News 28.7.2022
A research article published in the Frontiers in Remote Sensing journal presents a method for calculating local carbon dioxide and nitrogen oxide emissions. The method can be utilised in analysing the data of the CO2M satellites scheduled to be launched in 2025.
Photo: OHB
The…

原始发布时间: 2022-08-15
采集时间:
MIKES-FMI
An experimental campaign shows a variety of biological particles in the air and opens possibilities for their regular monitoring
A complex observational campaign in spring 2021 in Helsinki and Siauliai (Lithuania) combined several new observation methods, included machine learning…

原始发布时间: 2022-08-11
采集时间:
MIKES-FMI
A study by researchers at the Finnish Meteorological Institute has shown that the frequently repeated notion that "the Arctic region is warming at twice as fast as the rest of the globe" significantly underestimates the observed warming in the polar regions.
Nuuk, Greenland. Photo: Hada Ajosenpää…

原始发布时间: 暂无
采集时间:
COOMET
The 31st meeting of the COOMET Presidential Council was held online on 28 September 2022. Members of the Presidential Council from Belarus, Kazakhstan, Russia, as well as representatives of national secretariats of those countries took part in the meeting.
The following main outcomes of the…

原始发布时间: 暂无
采集时间:
COOMET
Round Table of Regional Legal Metrology Organizations took place on 27 September 2022 under the auspices of OIML, where representatives of all regional legal metrology organizations (RLMOs) took part alongside with CIML and BIML representatives. Valery Hurevich, COOMET President, represented…

原始发布时间: 暂无
采集时间:
NPL
3 minute read
Scientists at NPL have demonstrated the first in-person measurements of breast tissue using an innovative new detection technique, which has the potential to significantly improve breast cancer outcomes by aiding in the earlier diagnosis and treatment of the disease.The…


